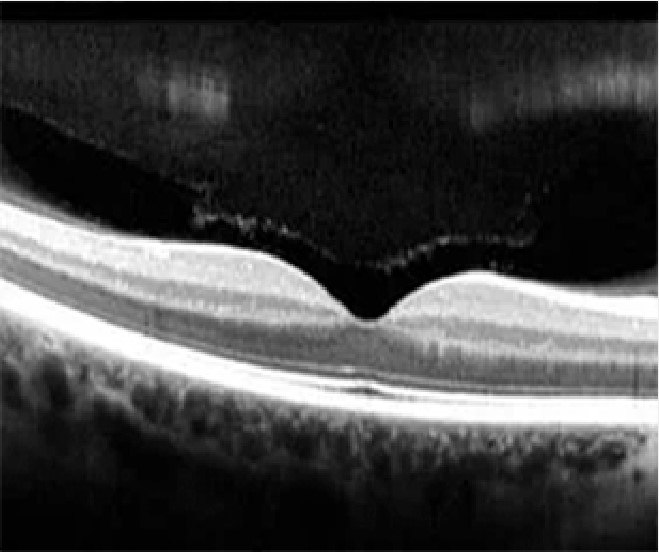
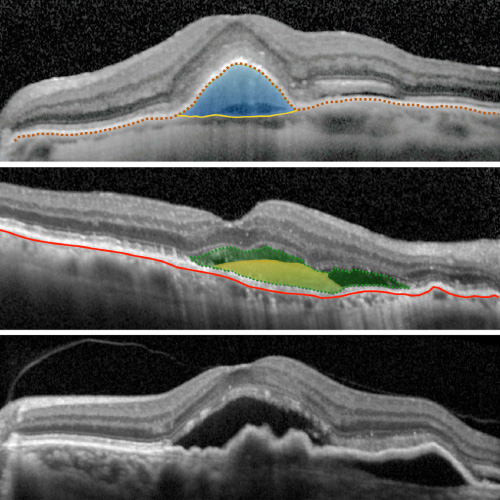
Tomografia OCT, Tomografía de Coherencia Optica
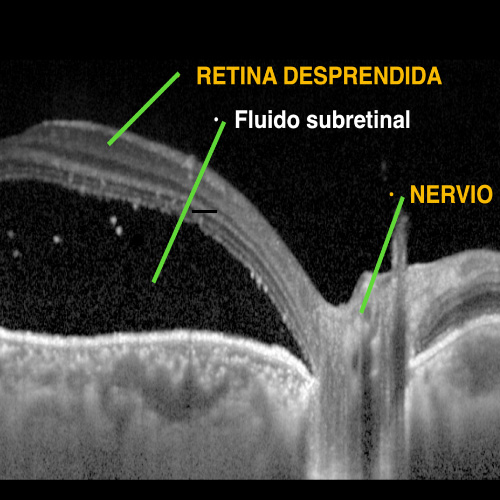
Tomografia OCT, Tomografía de Coherencia Optica
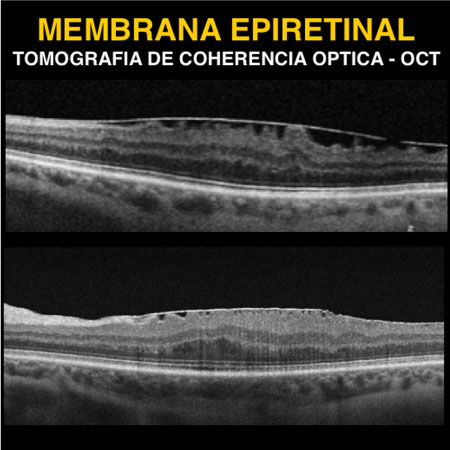
Tomografia OCT, Tomografía de Coherencia Optica

Tomografía de Coherencia Optica OCT
Somos especialistas en realizar el examen Tomografía de Coherencia Optica – OCT. Nuestros expertos oftalmólogos realizán el examen y diagnostican con alta precisión las enfermedades del ojo.
El OCT es el acrónimo en inglés de Optical Coherence Tomography, que español es Tomografía de Coherencia Óptica, es un estudio moderno que examina la estructura interna del ojo. Permite diagnosticar y hacer seguimiento de muchas enfermedades de la retina, mácula, nervio óptico, córnea, ángulo iridocorneal y conjuntiva.



Realizamos Tomografía de Coherencia Optica OCT altamente especializada en los segmentos anterior y posterior del ojo.
Diagnósticos precisos de la córnea, conjuntiva, iris y cámara anterior.

El examen se realiza en posición sentada, apoyando la barbilla en una mentonera.
EL proceso demora apenas 5 a 10 minutos y la obtención de las imágenes no ocasiona molestias y sólo se precisa mantener la mirada fija en el punto luminoso algunos segundos, por lo que incluso se puede realizar en niños.
La tomografía de coherencia óptica OCT es una herramienta que ayuda a diagnosticar miles de enfermedades del ojo

Examina las capas de fibra nerviosas de nervio óptico dañadas por el glaucoma
Analiza las alteraciones estructurales del Epitelio Pigmentario a nivel macular

Estudia la anatomía y las capas de la córnea, además de las alteraciones ultraestructurales

Evalúa la estructura de la retina y la mácula por el aumento de tamaño del ojo por la miopía

Estudia las alteraciones de la mácula producido por la diabetes

Estudia los cambios producidos en la conjuntiva por efecto de la inflamación y neoplasias

Análisis detallado de las fibras nerviosas que constituyen el nervio óptico
Diagnostica el despegamiento de la neuroretina del Epitelio Pigmentario de la Retina

Estudia la pérdida de continuidad de la neuroretina en la mácula

Análisis del desprendimiento seroso de la retina en la mácula
Examina la superficie retinal y los cambios producidos por la interfase vitreoretinal

Evalua las alteraciones producido por efecto de las fuerzas de tracción de la interfase vitreoretinal
(+51) 985 419 421
(+51) 932 416 223
(01) 479 6034
Av. Arequipa 2618 Oficina 603
San Isidro Lima – Perú
Lunes a Viernes: 9:00 am – 7:00 p.m. Sábados : 9:00 am – 2:00 pm